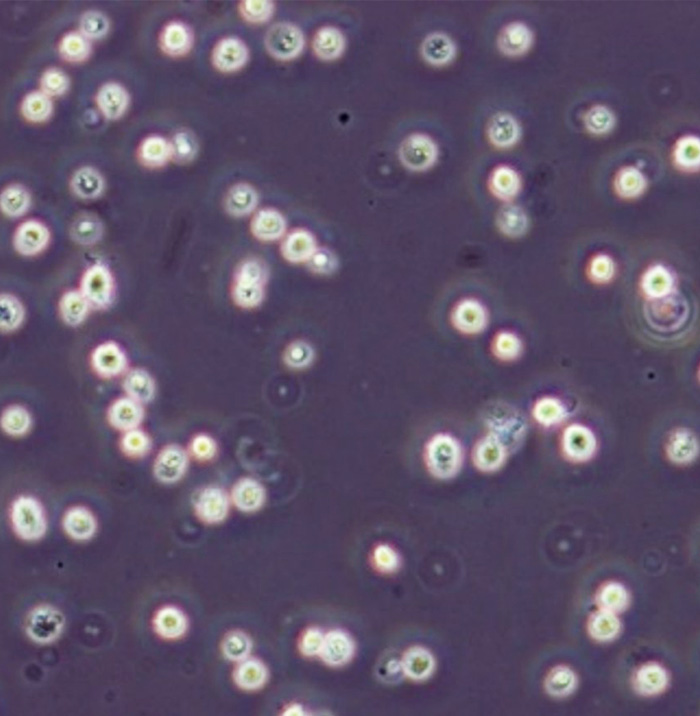

脂肪幹細胞移植とは
脂肪幹細胞とは、脂肪細胞周囲に存在するいろいろな細胞に分化することができる幹細胞を指します。脂肪になることもできますが、骨や軟骨、心筋細胞、血管などの組織や臓器に分化する能力があるため、再生医療の応用が期待されています。
脂肪幹細胞の主な働きには、創傷治癒、分化、免疫調節、新生血管形成、 痛みや腫れを抑える抗炎症作用などがあります。
脂肪幹細胞は、美容の分野でも応用されており、脂肪移植と併用することにより豊胸術(乳房増大術)、シワやたるみの悩みを解決させるアンチエイジングに使用されています。
まず、お腹や太ももといった脂肪が気になる部分から脂肪を吸引します。次に吸引した脂肪から幹細胞を抽出し、注入する脂肪と混ぜてボリュームを補いたい部位に注入することにより、ボリュームアップを図ります。
主に組織の修復、質感の改善、アンチエイジングを目的としています。
培養を行わない脂肪幹細胞の場合、脂肪吸引も同時にできることから、贅肉、気になる部分の脂肪を落とすことも可能です。
異物反応が少なく自然な仕上がりに
脂肪幹細胞移植が従来の脂肪注入法と異なるのは、脂肪の生着以外にも組織の再生(瘢痕組織の改善、組織の血流の改善など)を促すことができます。自分自身の細胞を使用するので、安全性に優れている手術と言えます。
ご自身の細胞であれば、既製品の薬剤などと比べて、体が拒否反応を示すこともありません。
脂肪幹細胞移植は自分の組織として定着するので、感触も良く自然な仕上がりとなります。脂肪の採取や移植はカニューレや針を用いて行いますので、傷は最小限で目立ちにくいです。
Method
有効性と安全性の高い治療法
脂肪幹細胞を用いた治療は日本がリードして行われています。その技術を当院も取り入れており、有効性や安全性は高いといえます。当院では細胞の凍結・解凍も行っており、使用したい分だけ解凍して注入を行っています。
【脂肪幹細胞移植の特徴】
・自身の脂肪組織を使用
・異物反応のリスクなし
・自分の組織となるので、仕上がりが自然
・同時に痩身治療が可能
・傷が目立ちにくい
Indication
こんなお悩みにおすすめです!
- ボリュームアップをしたい方
- 身体に異物を入れたくない方
- お腹や太ももなどの脂肪を減らしたい方
第三種再生医療等技術を取得しております。
牧野美容クリニックは、厚生労働省認定の特定認定再生医療等委員会に治療計画を提出して審査を経て認可された、脂肪幹細胞を用いた治療を行える美容医療クリニックです。
| 再生医療等の分類 | 第三種再生医療等技術 計画番号 : PC7220030 |
|---|---|
| 再生医療等の対象疾患等の名称 | 軟部組織の増大(顔面、体幹、陥凹部)及び 皮膚疾患・障害 (皮膚炎、瘢痕、拘縮、放射線障害) |
| 提供しようとする再生医療等の名称 | 自家脂肪組織由来細胞(脂肪由来幹細胞を含む)を用いた皮 膚・軟部組織の治療 |
Flow
施術の流れ
- 1. カウンセリング
施術前にまずは患者様のお肌の状態を観察し、医師が最適な提案をいたします。 - 2. 麻酔
お腹や太ももなど、脂肪を採取する部分を局所麻酔します。静脈麻酔や全身麻酔を併用します。 - 3. 採取した脂肪から脂肪幹細胞を抽出
採取した脂肪から幹細胞を抽出します。工程に2時間ほどかかります。 - 4. 注入
培養した幹細胞をボリュームアップしたい部位の皮下組織に注入します。 - 5. 帰宅
術後少し安静にしていただき、問題がなければご帰宅いただけます。
施術データ
| 施術時間 | 2時間 |
|---|---|
| 麻酔 | 局所麻酔、静脈麻酔 |
| ダウンタイム | 術後は数日~1週間ほど注入部分が腫れたり、内出血があったりします。 |
| シャワー、入浴 | 3日目から、入浴は1週間後から可能です。 |
| 化粧・洗顔 | 翌日から可能です。 |
| 通院回数 | 術後、脂肪注入部位にしこりや凹凸が見られるケースがあります。当クリニックではしこりが残りにくい施術を行っていますが、万が一術後しこりが気になる際は当クリニックにお知らせください。安全性が高く効果を実感しやすい施術ですが、脂肪の生着はどうしても個人差があるため、その点についてご理解いただければ幸いです。お仕事をしている方であれば、数日~1週間ほどお休みするのが望ましいと言えます。 |
施術後の注意点
術後、脂肪注入部位にしこりや凹凸が見られるケースがあります。当クリニックではしこりが残りにくい施術を行っていますが、万が一術後しこりが気になる際は当クリニックにお知らせください。
安全性が高く効果を実感しやすい施術ですが、脂肪の生着はどうしても個人差があるため、その点についてご理解いただければ幸いです。お仕事をしている方であれば、数日~1週間ほどお休みするのが望ましいと言えます。
メリット・デメリット、リスク
脂肪幹細胞を戻す施術は文献では
・週に2~3回のペースで戻して、約1ヶ月行う
・週に1回のペースで戻して約3ヶ月(14回)
とあります。組織移植のイメージでは週1回ペースの方が良いと思いますが、続けるのが難しい場合は週2〜3回ペースで良いと思います。
「培養なしの脂肪幹細胞」
◯メリット:コストが安い、初回は同日に注射できる。
◯デメリット:脂肪幹細胞のみの細胞数でないので、効果が落ちる。脂肪採取部の痛みや凹みなどの脂肪吸引に伴うリスクがある。
「培養ありの脂肪幹細胞」
◯メリット:純粋な脂肪幹細胞を注射できるので効果が高い。脂肪が少ない人でも治療を受けることができる
◯デメリット:コストが高い。培養期間が2ヶ月かかるので、2ヶ月余分に期間がかかる。
当クリニックの強み
当クリニックの強みは、学会活動や臨床経験が豊富な医師が施術することです。患者様に懇切丁寧に話を伺い、患者様の喜ぶ姿を思い描きながら、適切な施術を行っています。
理想の体を手に入れたい方、アンチエイジングに力を入れたい方でしたら、ぜひ当院にご相談ください。
施術費用
脂肪幹細胞治療(培養なし)
| 幹細胞作成料 | 598,000円/486,000円 |
|---|---|
| 幹細胞注入作業料/1回 | 55,000円 |
幹細胞注入作業料は一回の料金です。
脂肪幹細胞治療(培養あり)
| 細胞数/1,000万(半顔) | 425,000円 |
|---|---|
| 細胞数/3,000万(全顔1回分) | 695,000円 |
| 細胞数/5,000万(全顔2回分) | 775,000円 |
| 細胞数/1億(全顔4回分) | 975,000円/850,000円 |
| 細胞数/1.5億(全顔6回分) | 1,175,000円/1,020,000円 |
| 細胞数/2億(全顔8回分) | 1,375,000円/1,180,000円 |
| 幹細胞注入作業料 | 98,000円 |
※幹細胞作成料 - 培養幹細胞数
鼻
| 「培養ありの脂肪幹細胞」幹細胞は1億5千万 | 1,175,000円/980,000円 |
|---|
※培養期間:2ヶ月
※局所麻酔のため麻酔代は含まれます。
※幹細胞を戻すごとに:通常15,000円/回 モニター9,800円/回
※麻酔クリーム代込r